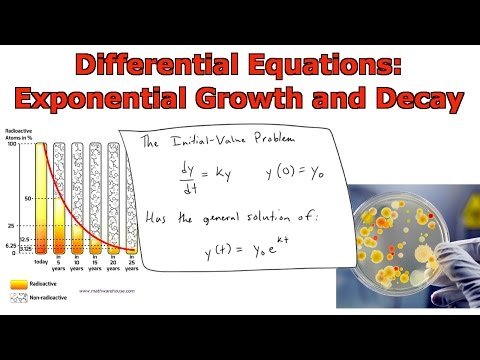
featured

jesusdpg (25)
Emprendedor, atleta
157 followers29 posts31 following0 HP
Blacklisted UsersMuted UsersFollowed BlacklistsFollowed Muted Lists
Blacklisted UsersMuted UsersFollowed BlacklistsFollowed Muted Lists
Venezuela Joined August 2018 Active 8 years ago